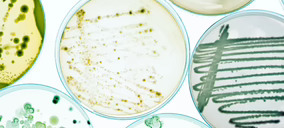
FourStrain Lab, fermentación de precisión con vocación industrial para ingredientes con sentido

Cocuus System Ibérica ha vuelto a recibir el respaldo de sus inversores para continuar avanzando en su propuesta de nuevas tecnologías y modelos productivos en el campo de las proteínas alternativas. La startup anuncia el cierre de una ronda por valor de 3 M€, que ha contado con la participación de Tech Transfer Agrifood, CDTI Innovación, Cargill y Big Idea Ventures.